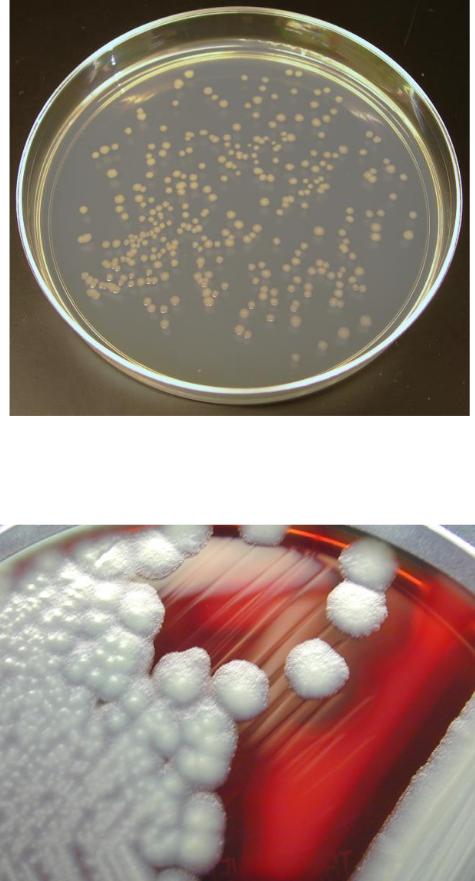

Лекция 8. 2 сем
.pdf
Палочки, образующие споры, называются бациллами и клостридиями.
У бацилл размер споры не превышает ширину клетки и поэтому при образовании споры форма клетки не меняется.
Бациллус – подвижные палочковидные клетки, обитают в почве.
Имеют жгутики, расположенные перитрихально.
Бациллы синтезируют различные литические ферменты,
расщепляющие полисахариды, белки, жиры и другие крупные молекулы.
Некоторые виды бацилл образуют антибиотики, такие как бацитрацин,
субтилизин.
Большинство бацилл сапрофиты, но есть и болезнетворные формы,
например, возбудитель сибирской язвы.
У клостридий диаметр споры больше толщины клетки и поэтому при созревании споры клетка приобретает форму веретена (если спора располагается в центре клетки) или барабанной палочки (если спора располагается на одном из полюсов клетки).
Клостридии осуществляют маслянокислое брожение.
Живут в почве, но некоторые виды в кишечнике человека и животных.
Есть опасные патогенные формы, например, возбудители столбняка,
газовой гангрены. C.botulinum вырабатывает смертельный токсин ботулин.
Рисунок 11. Схема строения споры: 1 – экзоспориум, 2 – слои споровой оболочки, 3 – внешняя мембраны споры, 4 – кора, 5 – внутренняя мембрана споры, 6 - сердцевина

Рисунок 12. Чистая культура Clostridium perfringens; видны субтерминально (указаны стрелками) и центрально расположенные опоры; окраска карболовым фуксином и метиленовым синим; х 800
Каждая клетка образует одну спору, которая служит для перенесения неблагоприятных условий.
Спора при соответствующих условиях (температура, влажность,
питательные вещества) прорастает, превращаясь в палочку.
Стойкость бактериальных спор превосходит стойкость любых живых организмов. Например, спора сенной палочки Bacillus subtilis выдерживает температуру 1000С в течение 3 ч. Такая устойчивость спор затрудняет борьбу с инфекциями.

Процесс превращения споры в растущую (вегетативную) клетку начинается с поглощения воды и набухания. При этом происходят глубокие физиологические изменения: усиливается дыхание и активизируются ферменты. В этот же период спора теряет свою термоустойчивость. Затем внешняя оболочка ее разрывается, и из образовавшейся структуры формируется вегетативная клетка.
Рисунок 13. Схемы образования спор

Рисунок 14. Схема образования спор у разных бактерий
8.5. Движение бактерий
Палочковидные бактерии бывают подвижные и неподвижные; клетки подвижных форм палочковидных бактерий снабжены специальными приспособлениями для движения – жгутиками.
Среди бактерий есть подвижные и неподвижные формы. Большинство подвижных бактерий активно передвигается только в жидкой среде.
Движение бактерий осуществляется:
С помощью жгутиков.
Жгутики имеют палочковидные бактерии и некоторые извитые формы.
Наличие жгутиков, их расположение являются постоянными для данного вида признаками и имеют диагностическое значение.
Некоторые виды бактерий имеют один жгутик (монотрихи), у других жгутики располагаются пучками на одном или обоих концах клетки

(политрихи), у третьих покрывают всю поверхность клетки (перитрихи).
Длина жгутиков может во много раз превышать длину клетки бактерий, достигая 10–30 мкм и более. Поперечный размер жгутиков составляет 0,01–0,03 мкм.
Скорость передвижения бактерий велика. За одну секунду клетка может пройти расстояние, в 20–50 раз превышающее длину ее тела.
Происходит движение при вращении жгутиков вокруг своей оси или за счет сокращения жгутиков.
• Путем скольжения.
Характерно для бактерий, имеющих слизистый чехол. За счет слизи клетка скользит по поверхности и передвигается.
• Путем ползания.
Передвижение осуществляется за счет сокращения всей клетки. Такой тип движения осуществляют спирохеты.
• Реактивное движение.
Некоторые бактерии для передвижения выбрасывают порции слизи, и
сами при этом отталкиваются.
а) |
б) |
в) |
Рисунок 15. Расположение жгутиков: а монотрихиальное |
||
расположение; |
|
|
б политрихиальное |
расположение; в |
перитрихиальное |
расположение

Большинство подвижных бактерий активно передвигается только в жидкой среде.
Жгутики имеют палочковидные бактерии и некоторые извитые формы.
Наличие жгутиков, их расположение являются постоянными для данного вида признаками и имеют диагностическое значение.
Длина жгутиков может во много раз превышать длину клетки бактерий,
достигая 10–30 мкм и более. Поперечный размер жгутиков составляет 0,01– 0,03 мкм.
Некоторые виды бактерий имеют один жгутик (монотрихи), у других жгутики располагаются пучками на одном или обоих концах клетки
(политрихи), у третьих покрывают всю поверхность клетки (перитрихи).
Скорость передвижения бактерий велика. За одну секунду клетка может пройти расстояние, в 20–50 раз превышающее длину ее тела.
Рисунок 16. Жгутики бактерий: 1 - монополярный монотрих (Vibrio); 2-
монополярные политрихи: а - Pseudomonas, в - (Chromatium), с - (Thiospiillum); 3 - биполярный политрих (Spiilum); 4 - перитрих (Proteus)
Происходит движение при вращении жгутиков вокруг своей оси или за счет сокращения жгутиков.

Рисунок 17. Жгутики грамотрицательных и грамположительных бактерий
Движение путем скольжения. Характерно для бактерий, имеющих слизистый чехол.
За счет слизи клетка скользит по поверхности и передвигается.
Путем ползания. Передвижение осуществляется за счет сокращения всей клетки. Такой тип движения осуществляют спирохеты.
Реактивное движение. Некоторые бактерии для передвижения выбрасывают порции слизи, и сами при этом отталкиваются.
8.6. Признаки, используемые при идентификации
микроорганизмов
Основные признаки, используемые при идентификации микроорганизмов:
-морфолого-цитологические признаки
-физиолого-биохимические признаки
- культуральные признаки
При идентификации бактерий рекомендуется также учитывать дополнительные признаки:
-серологические свойства,
-фагоустойчивость,
-химический состав клеточных стенок,
-содержание отдельных нуклеотидов в нуклеоиде.
Морфолого-цитологические признаки. К ним относятся:
-строение,
-форма и размеры клеток, их взаимное расположение,
-тинкториальные свойства (особенности при окрашивании различными красителями),
способность к образованию спор и капсул,
-подвижность,
-наличие жгутиков,
-образование в клетках некоторых включений,
-особенности размножения.
Физиолого-биохимические признаки. При изучении физиолого-
биохимических признаков устанавливают:
-отношение микроорганизмов к различным источникам углерода и азота,
-потребность в кислороде,
-температурные границы роста,
-солеустойчивость,
-чувствительность к антибиотикам,
-ферментативные тесты.

Культуральные признаки. К таким признакам относятся особенности роста микроорганизмов на плотных и жидких питательных средах.
Рисунок 18. Грам+ и Грамклетки бактерий
8.7. Колонии микроорганизмов на питательных средах
На плотных питательных средах бактерии образуют разные по форме и величине колонии - видимые скопления микроорганизмов одного вида,
которые формируются в результате размножения одной клетки.
Величина колоний, размеры колоний — признак, позволяющий различать различные виды, роды и даже типы бактерий. По величине колонии делятся на большие (4-5мм), средние (2-4 мм), мелкие (1-2мм).
В большинстве случаев колонии грамположительных бактерий мельче колоний грамотрицателъных.
Рисунок 19. Одиночные колонии бактерий на агаризованной среде
Рисунок 20. Одиночные колонии и колонии, слившиеся в «штрих»
